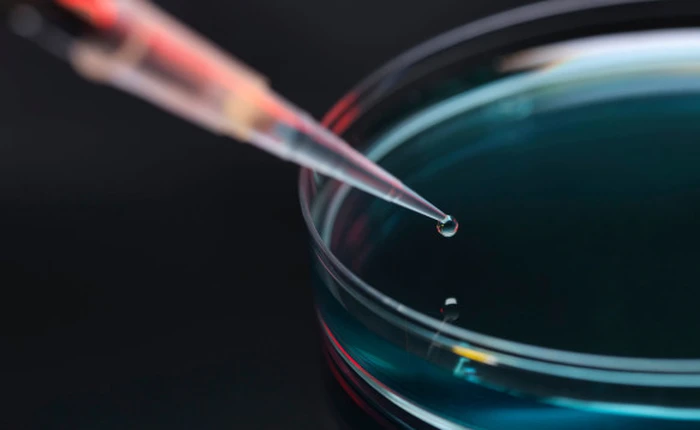
Google bắt đầu thay đổi cuộc sống con người từ việc trị tiểu đường

Chịu trách nhiệm quản lý nội dung: Bà Nguyễn Bích Minh
TRỤ SỞ HÀ NỘI: Tầng 22, Tòa nhà Center Building, Hapulico Complex, Số 01, phố Nguyễn Huy Tưởng, phường Thanh Xuân, thành phố Hà Nội
Điện thoại: 024 7309 5555.
Email: info@genk.vn
VPĐD TẠI TP.HCM: Tầng 4, Tòa nhà 123, số 127 Võ Văn Tần, Phường Xuân Hòa, TPHCM
© Copyright 2010 - 2026 - Công ty Cổ phần VCCorp
Tầng 17, 19, 20, 21 Toà nhà Center Building - Hapulico Complex, Số 01, phố Nguyễn Huy Tưởng, phường Thanh Xuân, thành phố Hà Nội
Giấy phép thiết lập trang thông tin điện tử tổng hợp trên mạng số 460/GP-TTĐT do Sở Thông tin và Truyền thông Hà Nội cấp ngày 03/02/2016

Hotline hỗ trợ quảng cáo:
Email: giaitrixahoi@admicro.vn
Hỗ trợ & CSKH: Admicro
Address: Tầng 20, Tòa nhà Center Building - Hapulico Complex, Số 01, phố Nguyễn Huy Tưởng, phường Thanh Xuân, thành phố Hà Nội